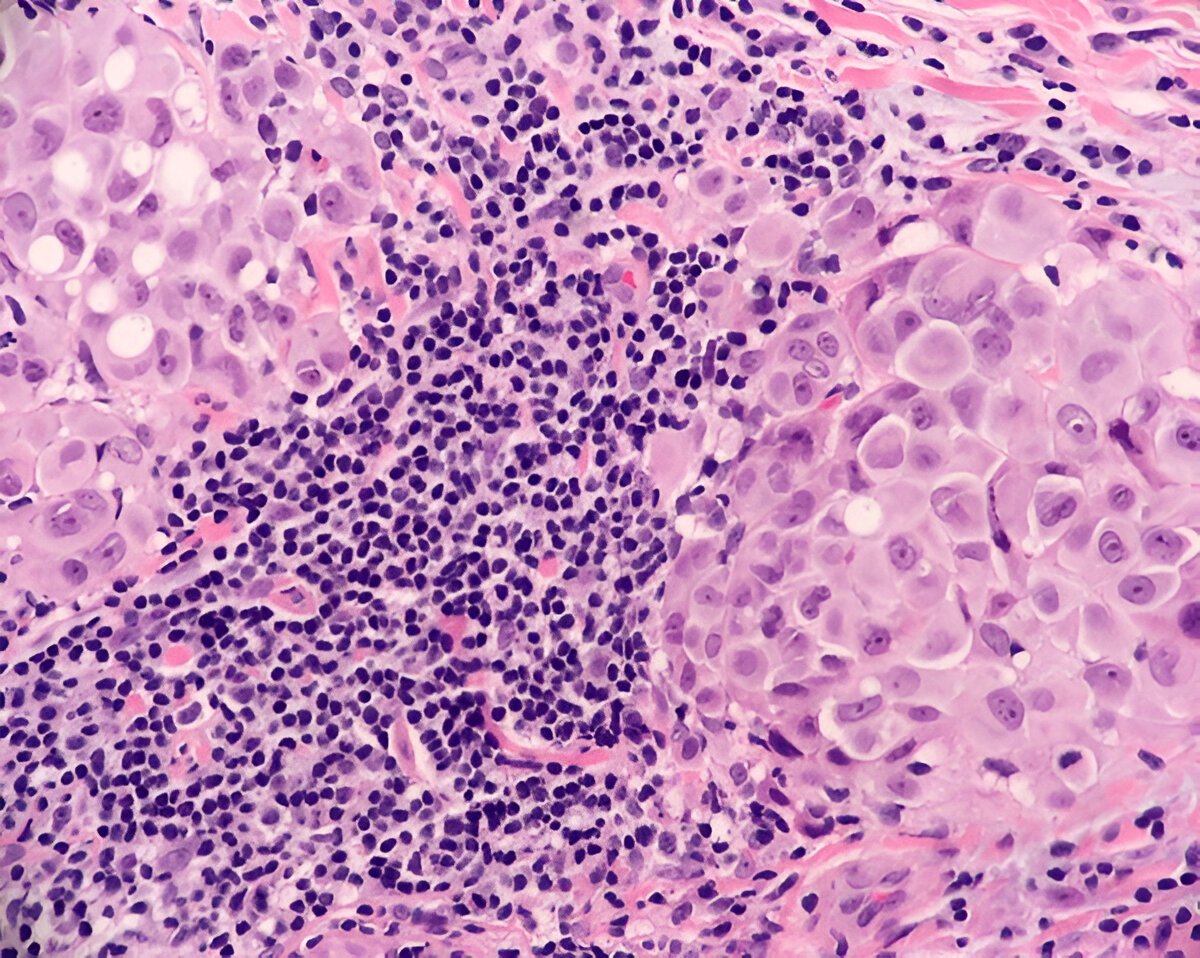

- Лімфогістіоцитарна інфільтрація це – загадка чи розгадка?
- Що таке лімфогістіоцитарна інфільтрація?
- Навіщо це потрібно знати?
- Як виявляється лімфогістіоцитарна інфільтрація?
- Типові сценарії виникнення
- У медичному контексті
- Аномалії та варіації
- Специфічні випадки
- Місцеві нюанси та акценти
- Локальні дослідження
- Що робити пацієнтам?
- Резюме
Лімфогістіоцитарна інфільтрація це – загадка чи розгадка?
Лімфогістіоцитарна інфільтрація це… що? Ні, ви тільки подивіться на цю фразу. Тут обіцяють щось складне, заплутане, але цікавезне. І так воно є. Тема наша сьогодні непроста, але спробуймо розібратися. Отже, почнемо!
Що таке лімфогістіоцитарна інфільтрація?
Цей термін описує один із типів клітинної реакції організму. Коли організм зустрічається з проблемою – інфекція, травма чи щось інше, – наші імунні системи вирушають на бойові позу. Лімфоцити та гістіоцити прагнуть вторгнутися в уражені тканини, щоб вирішити проблему.
- Лімфоцити: Це білі кров’яні клітини, що відіграють роль солдат у нашій захисній системі.
- Гістіоцити: Їх ще називають макрофагами, і вони спеціалізуються на поїданні мікробів і утилізації мертвих клітин.
Навіщо це потрібно знати?
Запитання, те саме! Наше здоров’я — це як детективний роман, де кожна клітина відіграє важливу роль. Лімфогістіоцитарна інфільтрація допомагає розуміти, як працює наше тіло в разі проблем. Особливо це важливо для лікарів, які щодня намагаються знайти відповідь на питання, чому пацієнт почувається не так, як треба.
Як виявляється лімфогістіоцитарна інфільтрація?

Основні способи — це біопсія та аналіз крові. Лікарі беруть зразок тканини та вивчають його під мікроскопом. Сподіваюся, ви розумієте, що це не виглядає як у популярних серіалах, де все виглядає надто спрощено. Тут потрібен справжній дар знаходити ці клітини серед багатьох інших.
Типові сценарії виникнення
- Інфекції: Тут все очевидно – інфекція, біленькі хлопці (лімфоцити) намагаються її зупинити. Вія трохи схоже на військову операцію, тільки без танків та літаків.
- Аутоімунні захворювання: Інколи наші війська плутають друзів із ворогами і атакують власні тканини. Хіба це не трагічний момент?
- Запальні процеси: Організм вирішує, що в певному місці щось іде не так, і намагається все владнати, розсилаючи туди лімфоцити та гістіоцити.
У медичному контексті
Для лікарів лімфогістіоцитарна інфільтрація – це частина повсякденної роботи. Наприклад, при діагностиці хвороб легень, печінки або шкіри можна виявити її, що дозволяє визначити правильність діагнозу. Як казали мудрі, знання – це сила!
Аномалії та варіації
Коли говоримо про варіації, то свідомість відразу малює карту світу з різнокольоровими точками. У випадку лімфогістіоцитарної інфільтрації відзначаються такі варіації, що навіть найдосвідченіші лікарі іноді переводять дух.
Специфічні випадки
Іноді цей процес може бути ознакою рідкісних захворювань, напрочуд не схожих між собою. І ви розумієте, що це не просто цікаво, а ще й вкрай важливо – адже кожна зайва клітина, що ненароком проникає куди не слід, може бути важливим індикатором. Нічого не можна залишати без уваги, навіть якщо воно здається незначним.
Місцеві нюанси та акценти
При розгляді цієї теми слід також зважати на локальний контекст. У кожному регіоні можуть бути свої специфічні випадки та підходи до лікування, на що варто звертати увагу.
Локальні дослідження
Наприклад, на заході України можуть бути зовсім інакші умови для виникнення лімфогістіоцитарної інфільтрації порівняно з Карпатським регіоном. Різні екологічні фактори, рівень забрудненості, стиль життя — усе це відіграє роль.
Що робити пацієнтам?
Для тих, хто не в халатах, а лише намагається зрозуміти, що з ними коїться. Не переймайтеся надто сильно, якщо відчуваєте схожі симптоми. Знайдіть того єдиного лікаря, якому довіряєте, і розкажіть про все у найменших деталях.
- Перевіряйтеся регулярно: Не чекайте, поки вставлять крапельницю на 10 днів, щоб щось з’ясувати. Профілактика — це ваше все.
- Не бійтесь питати: Коли щось не біса ясно, перепитуйте лікаря до перемоги. Він же там не для краси, а для допомоги.
Резюме
То що ж, ця інфільтрація складна й заплутана? Ще й як. Але чи не на неї ми можемо покластися в розумінні свого організму? Безперечно так. Лімфогістіоцитарна інфільтрація — це таємничий пісок у годиннику здоров’я, без якого знання про власне тіло були б неповними. Питання лише в тому, чи готові ви звертати увагу на такі деталі?





